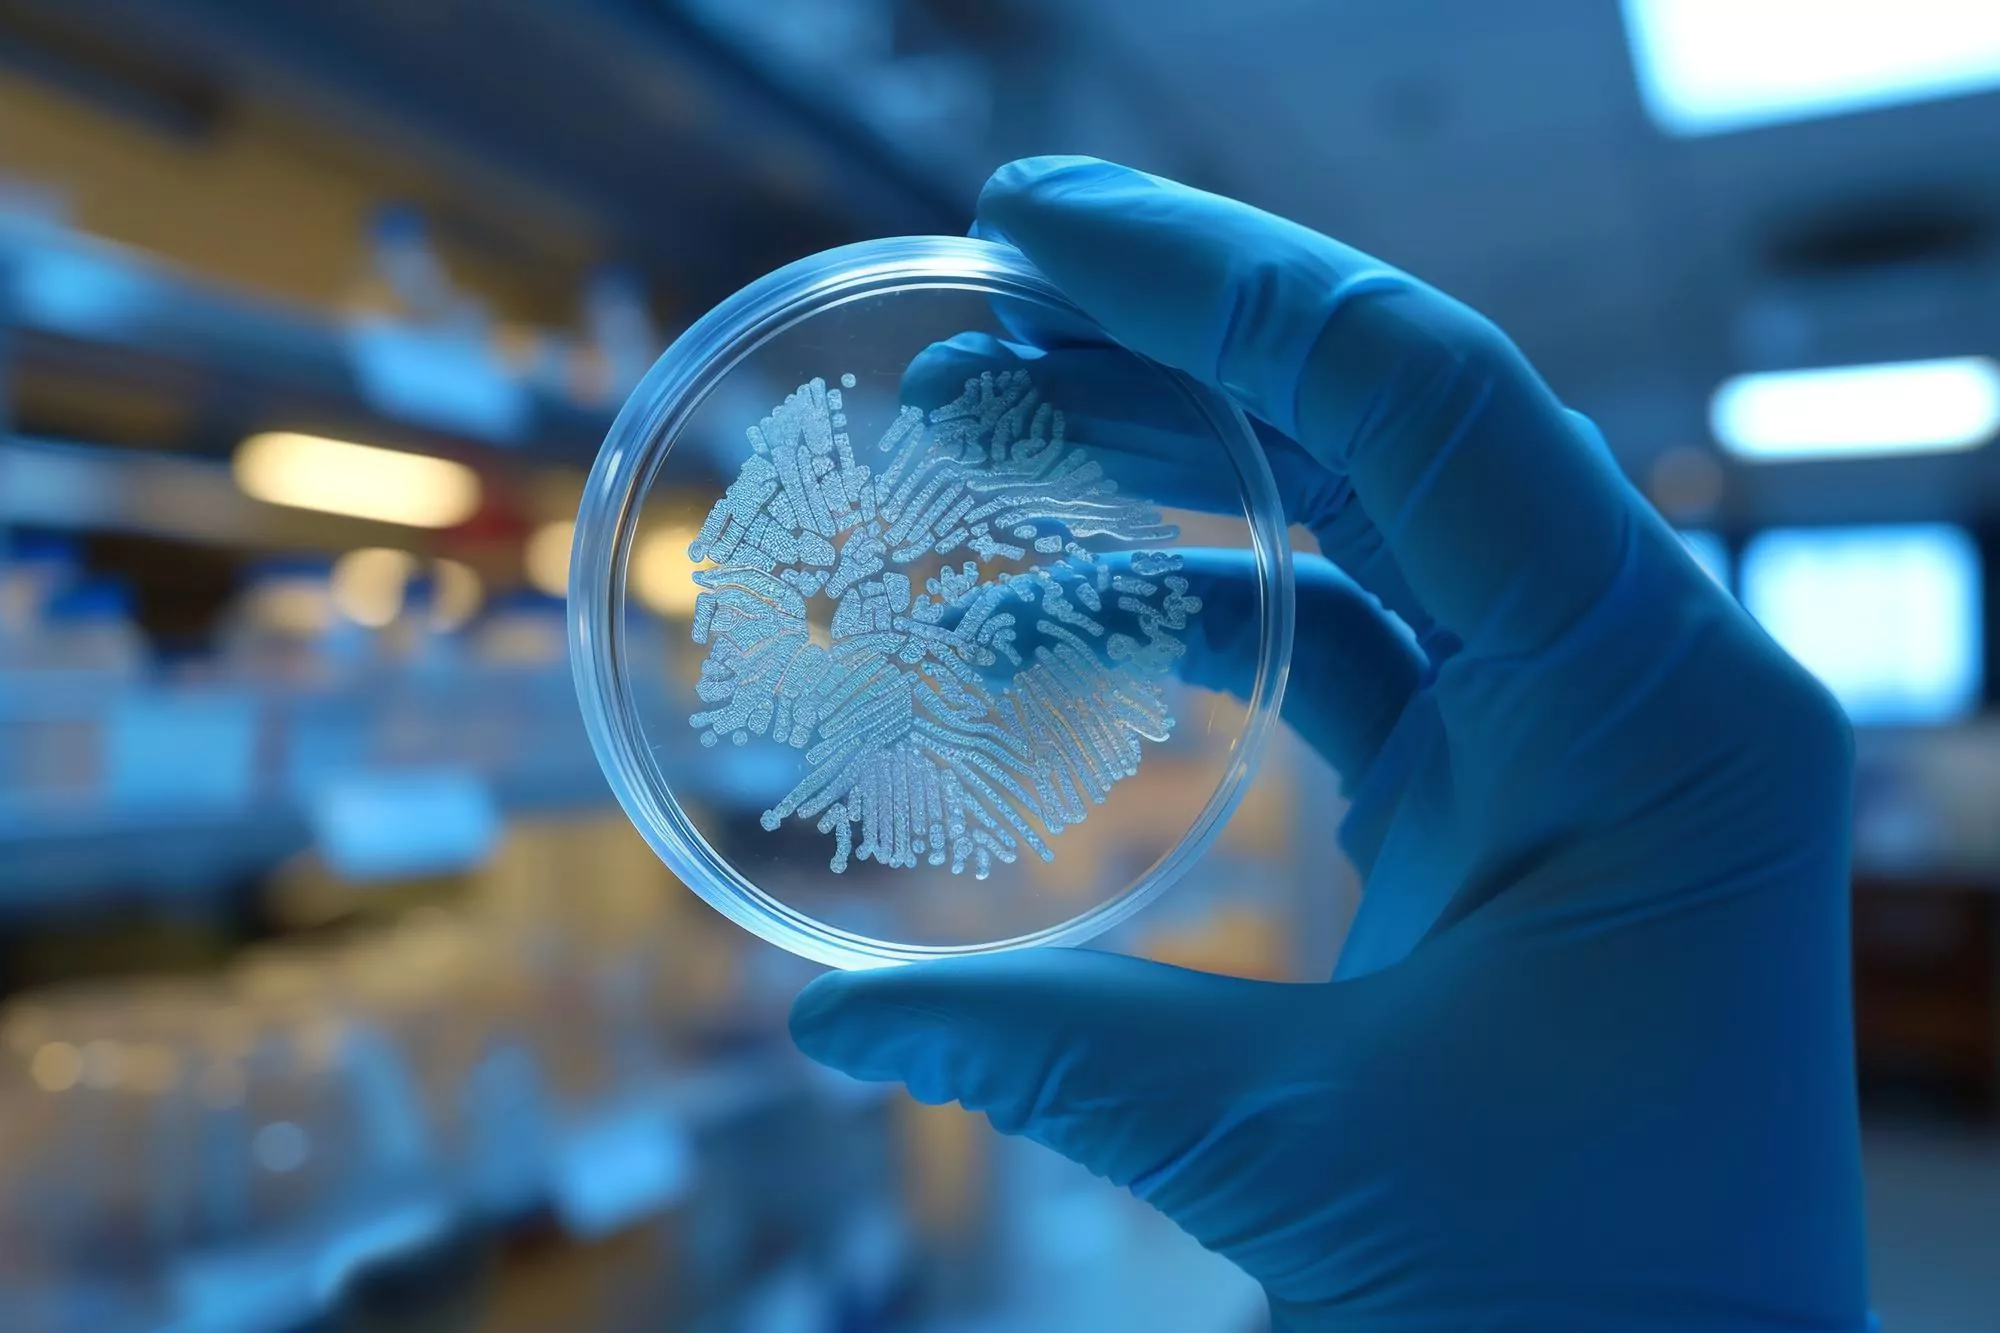
Bacterial

A medical team from Teikyo University Chiba Medical Center, Japan, has announced a significant achievement in the diagnosis and treatment of peritonitis caused by Roseomonas mucosa. This milestone marked by the therapeutic success in a 70-year-old woman’s case with peritoneal dialysis (PD)-related peritonitis provides hope and a new direction for handling infections with hard-to-identify pathogens.
Peritonitis, an inflammation of the peritoneum often triggered by infection, can pose a significant risk, particularly to individuals undergoing peritoneal dialysis—a life-sustaining treatment for patients suffering from severe chronic kidney disease. In the delicate environment where PD operates, any infection can turn into a life-threatening emergency. The culprit in this case, Roseomonas mucosa, a pink-pigmented bacterium, is notorious for its elusive nature. Traditional diagnostic techniques typically fall short in accurately identifying this bacterium, posing a significant challenge to clinicians in recognizing and treating the associated infections effectively.
However, by utilizing state-of-the-art diagnostic technologies, the medical team was able to pinpoint the offending pathogen. Matrix-assisted laser desorption/ionization-time-of-flight (MALDI-TOF) mass spectrometry (MS) played a pivotal role in identifying the organism that traditional methods had failed to detect. This high-precision technique provides a faster and more accurate diagnosing capability, which is crucial in managing infections in a timely and targeted manner.
The patient presented with typical signs of PD-related peritonitis and was promptly admitted to the hospital. When the blood agar medium of the dialysate culture produced a colony with a distinctive pale pink color, suspicion arose concerning the nature of the microorganism. Using the cutting-edge MALDI-TOF MS, the team achieved a definitive identification of R. mucosa.
This breakthrough allowed for a targeted treatment approach. The patient was administered a combination of ciprofloxacin and meropenem, a regimen that proved effective without necessitating the removal of the PD catheter. Such optimal outcomes are a rarity since the managing of infections by non-mainstream pathogens, such as R. mucosa, often results in technique failure or the need for invasive actions like the removal of catheters or devices.
The success story reported in the journal ‘Internal Medicine (Tokyo, Japan)’ under the doi: 10.2169/internalmedicine.2998-23 is hopeful news for patients undergoing PD and the physicians treating them. The researchers, Nariyama Tomoyuki, Ito Yasuko, Fujita Koji, Ito Takafumi, and Terawaki Hiroyuki, have effectively pushed the envelope, setting a precedent in the field of infectious diseases and nephrology.
Implications and Future Directions
This case not only reaffirms the necessity of advanced diagnostic tools in modern medicine but also potentially transforms the standard treatment protocol for peritonitis caused by rare and difficult-to-identify organisms. MALDI-TOF MS could thus become a staple in clinical laboratories, empowering clinicians with greater precision and accuracy.
Beyond the immediate results, such successful treatment protocols that preclude the need for removing PD catheters also mean improved quality of life for patients and reduced health care costs. By avoiding invasive procedures, there is a significant improvement in the overall experience and outcome for individuals suffering from chronic conditions requiring PD.
References
1. Internal Medicine (Tokyo, Japan) Journal Article (2024). A Case of Successfully Treated Roseomonas mucosa-induced Peritonitis Diagnosed by Mass Spectrometry.
2. Adequacy of peritoneal dialysis: Integrating certain key factors in evaluating treatment effectiveness, Nephrology Dialysis Transplantation.
3. The Role of MALDI-TOF MS in infectious diseases, Clinical Microbiology and Infection.
4. PATOS: Recent advancements in identifying peritonitis-causing organisms in PD patients, American Journal of Kidney Diseases.
5. Optimization of empirical antibiotic therapy in peritoneal dialysis-associated peritonitis, Kidney International Reports.
Keywords
1. Roseomonas mucosa peritonitis
2. MALDI-TOF mass spectrometry diagnosis
3. Peritoneal dialysis infection treatment
4. Advanced bacterial identification techniques
5. Reducing catheter removal in PD patients
The article not only raises awareness about a seldom-discussed pathogen but equally showcases the progressive steps medicine is taking in the fight against resilient microbial adversaries. It stands as a testament to the evolving landscape of healthcare and the role that cutting-edge technologies continue to play in improving patient outcomes. With this pioneering case, the Teikyo University Chiba Medical Center has indeed etched a mark in the medical community, providing enriching literature for forthcoming research and clinical practices.